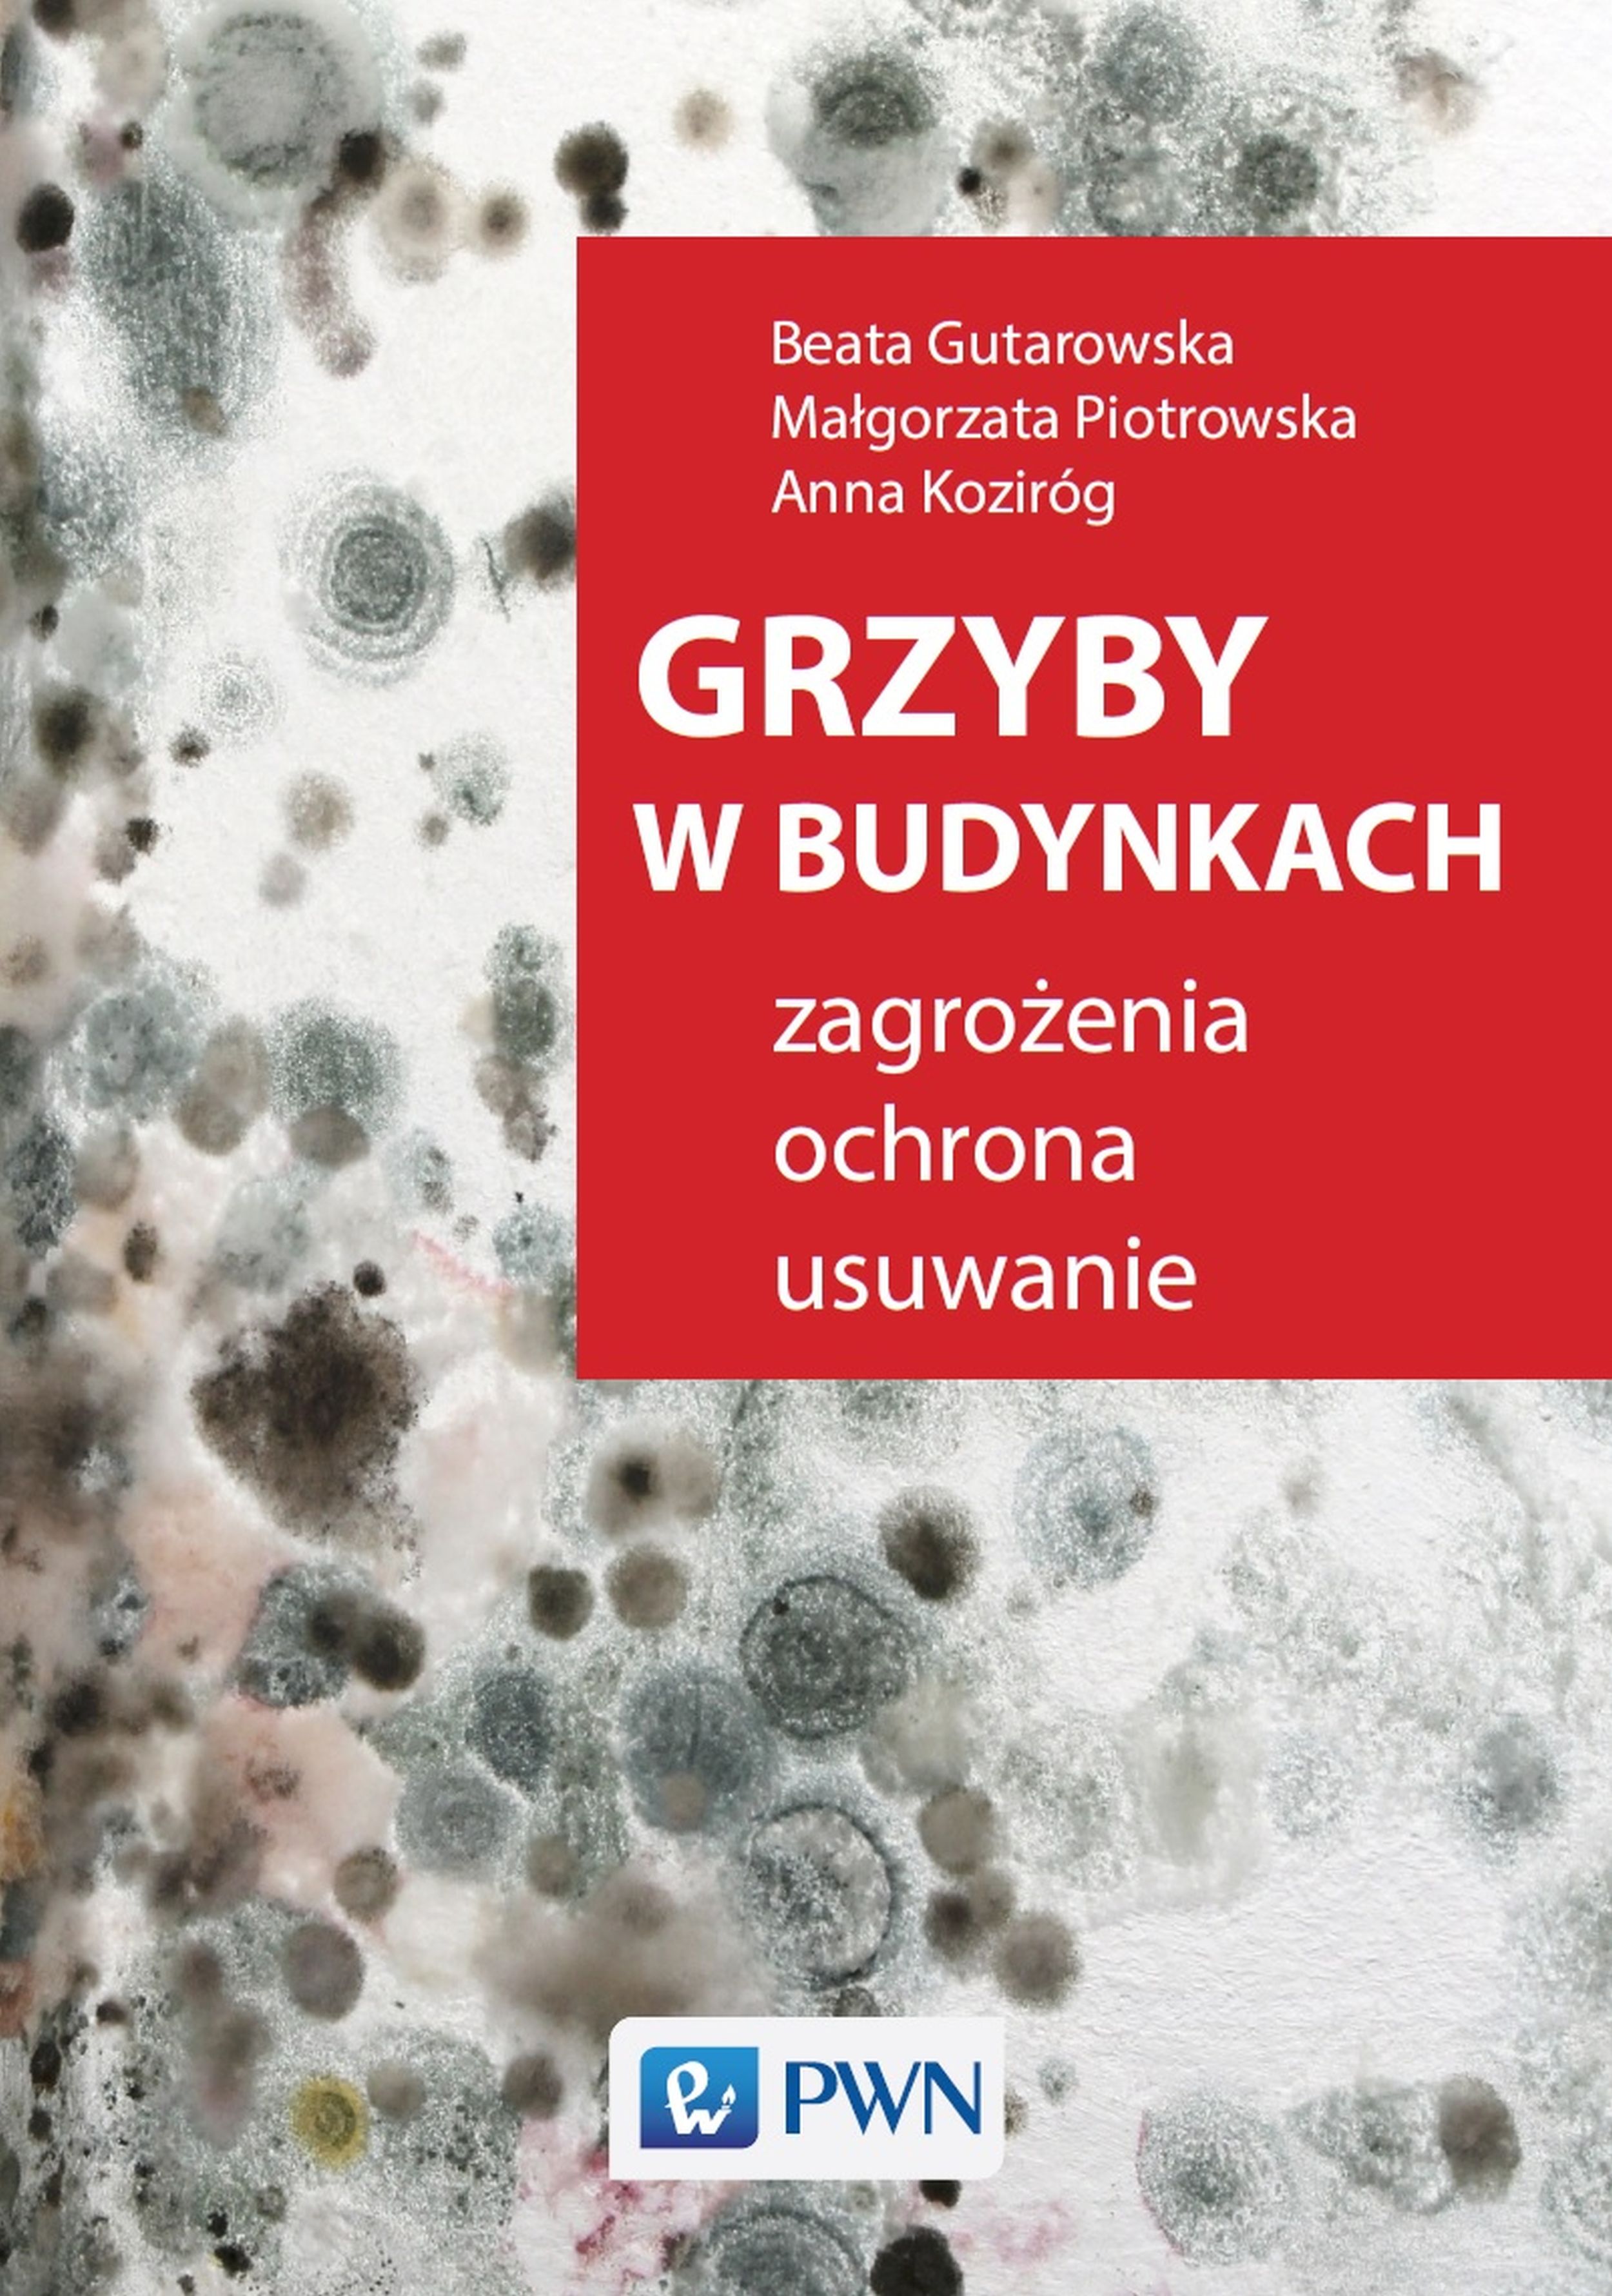

Zjawisko zagrzybienia w budownictwie jest poważnym problemem dotykającym zarówno obiekty nowe jak i zabytkowe. Rozwój grzybów stanowi zagrożenie z punktu widzenia strat ekonomicznych i kulturowych, ale głównie jest zagrożeniem dla zdrowia użytkowników. Ważne jest zatem kompleksowe podejście do tego zagadnienia, obejmujące nie tylko charakterystykę czynników biotycznych i abiotycznych korozji biologicznej, ale również działania prewencyjne i naprawcze.
Niniejsza publikacja przedstawia metody badań stanu zanieczyszczenia powietrza i powierzchni w pomieszczeniach budowlanych, w których wystąpiły objawy rozwoju pleśni. Prezentuje także sposoby usuwania grzybów pleśniowych oraz zabezpieczania przed ich powstawaniem.
Książka dedykowana jest studentom budownictwa, ochrony środowiska, biotechnologii, BHP, medycyny, chemii budowlanej, konserwacji dzieł sztuki, a także administratorom budynków użyteczności publicznej oraz budowlanych obiektów zabytkowych. Powinna zainteresować także pracowników firm budowlanych zajmujących się odgrzybianiem.
"Nie wszyscy zdajemy sobie sprawę jak szkodliwe jest narażanie organizmu na bezpośredni kontakt z rozwijającymi się w pomieszczeniu pleśniami i wytwarzanymi przez nie związkami toksycznymi. Autorki zaprezentowały aktualną wiedzę na temat przyczyn i skutków rozwoju pleśni w pomieszczeniach, w których przebywa człowiek, a także sposobów jej usuwania."
prof. dr hab. inż. Zofia Żakowska